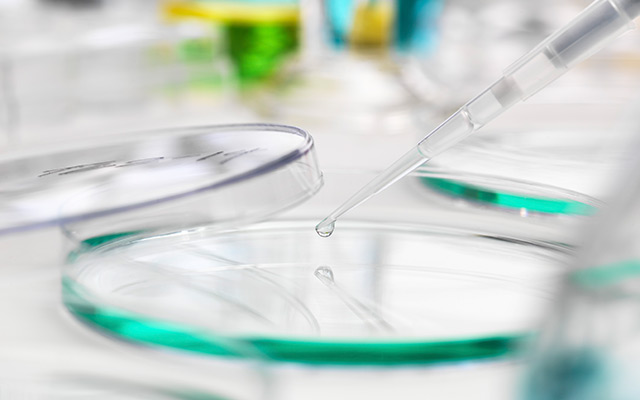
티타늄 리프팅

강남, 청담까지 갈 필요가 전혀 없습니다.
세포재생의 시작과 끝, 혈액 유래 줄기세포 주사는 혈액에서
성체줄기세포를
분리, 농축하여 배양과정 없이, 피부에 직접 주입하는 시술입니다.
배양과정이 필요 없어 감염, 면역거부반응 등의 위험이 없고 노화로 인한
세포의 기능 저하와
혈관 내피와 손상된 조직의 재생, 산소와 영양분을 공급해
신체의 기능을 향상시킵니다.
세포에서부터 시작하는 근본적 안티에이징
줄기세포는 신체를 구성하는 여러 종류의 세포로 분화할 수 있는 성장인자를
가진 세포로써 우리 몸의 조직이나 기관의 특수한 기능을 가진 세포로 발달할 수 있는
잠재력을 가지고 있습니다. 치료가 필요한 체내 특정 조직의 세포로 분화하여 손상 세포를
치유하고 노화된 세포를 젊은 세포로 재생 시키는 것이 줄기세포 치료의 핵심입니다.
세포재생의 시작과 끝, 혈액 유래 줄기세포 주사는 혈액에서
성체줄기세포를
분리, 농축하여 배양과정 없이, 피부에 직접 주입하는 시술입니다.
배양과정이 필요 없어 감염, 면역거부반응 등의 위험이 없고 노화로 인한
세포의 기능 저하와
혈관 내피와 손상된 조직의 재생, 산소와 영양분을 공급해
신체의 기능을 향상시킵니다.
신의료 국가인증 줄기세포추출 첨단시스템으로
손상없이, 고농도의 줄기세포와 함께 재생에 필수적인
성장인자, 백혈구, 혈소판, SDF1-a 등의 세포와 함께
생존률 최대 98%의 세포를 아끼지 않고 사용합니다.





주름, 탄력, 피부톤 등
복합적인 안티에이징 시술이
필요하신 분
기존 피부시술로
효과를 보지 못하신 분
일시적 효과가 아닌
근본적인 안티에이징 시술이
필요하신 분
오랫동안 효과가
유지되는 피부 시술을
희망하시는 분
만성피로·수면장애로
회복이 느린 분
시술·수술 후
빠른 회복이 필요한 분
슬로우에이징과 항노화 케어를
미리 시작하고 싶은 분
내 안의 아름다움을 찾아드립니다.
